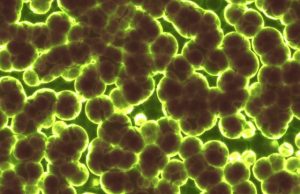
A simple rule drives the evolution of useless complexity A simple rule drives the evolution of useless complexity

Karina
Shocking adaptations discovered in electric fish of Brazil’s Amazon
A study of weakly electric fishes from a remote area of the Brazilian Amazon Basin has not only offered a unique window into how...
New study helps pinpoint when earth’s plate subduction began
A new study from scientists at Scripps Institution of Oceanography at UC San Diego and the University of Chicago sheds light on a hotly...
The greening of the Earth is approaching its limit
When plants absorb this gas to grow, they remove it from the atmosphere and it is sequestered in their branches, trunk or roots. An...
Hubble pins down weird exoplanet with far-flung orbit that behaves like...
A planet in an unlikely orbit around a double star 336 light-years away may offer a clue to a mystery much closer to home:...
Single-crystal technology holds promise for next-generation lithium-ion batteriesSingle-crystal technology holds promise...
A promising technology under development by major battery makers has become even more attractive, thanks to researchers who have taken an unprecedented look at...
High-precision measurements of the strong interaction between stable and unstable particles
The positively charged protons in atomic nuclei should actually repel each other, and yet even heavy nuclei with many protons and neutrons stick together....
New evidence: Neandertals buried their dead
Was burial of the dead practiced by Neandertals or is it an innovation specific to our species? There are indications in favor of the...
Manmade mass now outweighs life on Earth: study
For the first time in history manmade materials now likely outweigh all life on Earth, scientists said Wednesday in research detailing the "crossover point"...
Tomatoes offer affordable source of Parkinson’s disease drug
Scientists have produced a tomato enriched in the Parkinson's disease drug L-DOPA in what could become a new, affordable source of one of the...
A simple rule drives the evolution of useless complexity
A new study at the University of Chicago has shown that elaborate protein structures accumulate over deep time even when they serve no purpose,...
Fatty residues on ancient pottery reveal meat-heavy diets of Indus Civilization
New lipid residue analyses have revealed a dominance of animal products, such as the meat of animals like pigs, cattle, buffalo, sheep and goat...